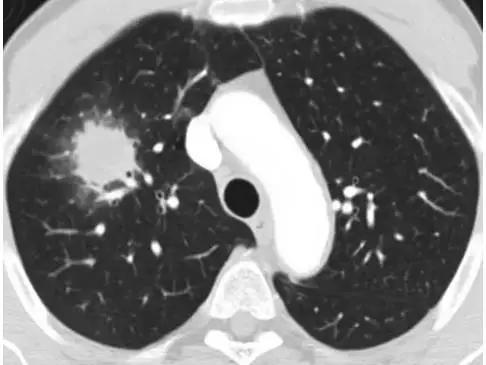
\

SCI论文(www.lunwensci.com):
【摘要】 目的:氨溴索联合泼尼松治疗特发性肺间质纤维化(IPF)急性加重期患者的效果。 方法: 选取 148 例 IPF 急性加重期患 者作为研究对象,按照随机数字表法分为观察组和对照组各 74 例。对照组采取泼尼松治疗,观察组在对照组基础上联合氨溴索治疗。两 组均治疗 3 个月,比较两组临床疗效、治疗前后血气指标 [ 动脉血氧分压(PaO2) 、动脉血二氧化碳分压(PaCO2)、 pH] 水平和不良反 应发生率。 结果: 观察组治疗总有效率为 98.65%,高于对照组的 86.49%,差异有统计学意义(P<0.05) ;治疗后,观察组 PaO2 、pH 水 平均高于对照组, PaCO2 水平低于对照组, 差异有统计学意义(P<0.05); 两组不良反应发生率比较, 差异无统计学意义(P>0.05)。 结论: 氨溴索联合泼尼松治疗 IPF 急性加重期患者,可提高治疗总有效率,改善血气指标水平,效果优于单纯泼尼松治疗。
【关键词】 氨溴索;泼尼松;特发性肺间质纤维化;急性加重期;血气指标;不良反应
Effects of Ambroxol combined with Prednisone in treatment of patients with acute exacerbation of idiopathic pulmonary interstitial fibrosis
WU Yanhong
(The Third Department of Internal Medicine of Chaoyang County Central Hospital, Chaoyang 122000 Liaoning, China)
【Abstract】 Objective: To observe effects of Ambroxol combined with Prednisone in treatment of patients with acute exacerbation of idiopathic pulmonary interstitial fibrosis (IPF). Methods: 148 patients with acute exacerbation of IPF were selected as the research objects, and were divided into observation group and control group according to the random number table method, 74 cases in each group. The control group was treated with Prednisone, while the observation group was treated with Ambroxol on the basis of that of the control group. Both groups were treated for 3 months. The clinical efficacy, the blood gas indexes [partial pressure of oxygen (PaO2), partial pressure of carbon dioxide (PaCO2), pH] levels and the incidence of adverse reactions were compared between the two groups before and after the treatment. Results: The total effective rate of treatment in the observation group was 98.65%, which was higher than 86.49% in the control group, and the difference was statistically significant (P<0.05). After the treatment, the PaO2 and pH levels of the observation group were higher than those of the control group; the PaCO2 level was lower than that of the control group; and the differences were statistically significant (P<0.05). However, there was no statistically significant difference in the incidence of adverse reactions between the two groups (P>0.05). Conclusions: Ambroxol combined with Prednisone in the treatment of the patients with acute exacerbations of IPF can increase the total effective rate of treatment and improve the levels of blood gas indicators. Moreover, it is superior to single Prednisone treatment.
【Key words】 Ambroxol; Prednisone; Idiopathic pulmonary interstitial fibrosis; Acute exacerbation period; Blood gas indicators; Adverse reaction
特发性肺间质纤维化(IPF)属于慢性炎症型 肺间质疾病,其发病机制尚不明确 [1-2] 。临床发现, IPF 早期通常表现为肺泡病变,后期由于成纤维细 胞的增生破坏患者的肺泡结构,患者若不及时予以 科学医治,可能进展为弥漫性的间质性肺纤维化, 最终危及生命 [3-4] 。以往临床常采用糖皮质激素类 药物治疗,但单一用药停药后的复发率相对较高。 氨溴索具有抗氧化及降低炎性介质释放的作用,同 时对肺组织有较好的保护作用。本文观察氨溴索联合泼尼松治疗 IPF 急性加重期患者的效果。
1 资料与方法
1.1 一 般 资 料 选 取 2020 年 3— 10 月本院收治 的 148 例 IPF 患者作为研究对象。纳入标准:符合 IPF 急性发作期诊断标准 [5] ;结合病史、血清学、 X 线片和高分辨率 CT 检查等确诊;近 1 个月内存 在不明原因的呼吸困难, 且肺功能呈急剧恶化状态; 气道分泌物和肺泡灌洗液经病原学诊断呈阴性;年 龄 >50 岁。排除标准:其他类型的肺部疾病;恶性 肿瘤;存在心脑血管病、血液疾病、严重的免疫性 疾病;肝肾功能障碍。患者及其家属对本研究内容了解并自愿签署知情同意书,且研究经本院伦理委员会批准(批准文号 020013)。按照随机数字表法分成观察组和对照组各 74 例。观察组男 43 例,女 31 例;年龄 51~83 岁,平均(65.34±3.60)岁;病程 5~9 个月,平均(7.06±0.72)个月;急性发作时间 2~6 d,平均(4.29±0.44)d;体质量指数(BMI)19~23 kg/ m2
,平均(21.03±1.14)kg/m2。对照组男 40 例,女 34 例;年龄 51~84 岁,平均(65.30±3.49)岁;病程 5~10 个月,平均(7.13±0.69)个月;急性发作时间 2~7 d,平均(4.32±0.37)d;BMI 19~24 kg/m2,平均(21.01±1.16)kg/m2。两组一般资料比较,差异无统计学意义(P>0.05),有可比性。
1.2 方法 两组均实施常规机械通气和吸氧,以及抗凝和纠正水电解质紊乱等措施。在此基础上,对照组予以醋酸泼尼松片(浙江仙琚制药股份有限公司,国药准字H33021207,5 mg),0.5 mg/(kg·d),分 3 次口服,1 个月后剂量减至 0.25 mg/(kg·d),再过 1 个月继续减至 0.125 mg/(kg·d),维持此剂量服用 1 个月。观察组在对照组基础上联合盐酸氨溴索片(北京太洋药业股份公司,国药准字H20010483,30 mg)治疗,口服,30 mg/次,3次/d。两组均治疗 3 个月。
1.3 观察指标 (1)比较两组临床疗效 [6]。显效:治疗后,咳嗽、咳痰及肺部啰音等症状体征消失,X 线片正常;有效:治疗后,咳嗽、咳痰及肺部啰音等症状体征有所减轻,X 线片或高分辨率CT 检查显示异常影像减少;无效:未达到上述标准。治疗总有效率 =(显效 + 有效)例数 / 总例数×100%。(2)比较两组治疗前后血气指标水平,包括动脉血氧分压(PaO2)、动脉血二氧化碳分压(PaCO2)和 pH,采用美国 MEDICA 公司生产的全自动血气分析仪测定。(3)比较两组不良反应发生率。
1.4 统计学方法 应用 SPSS 21.0 软件进行统计学分析,计量资料以(x—±s)表示,采用 t 检验,计数资料以率(%)表示,采用 χ2 检验,以 P<0.05为差异有统计学意义。
2 结果
2.1 两组临床疗效比较 观察组治疗总有效率为98.65%(73/74),明显高于对照组的86.49%(64/74),
差异有统计学意义(P<0.05)。见表 1。
2.2 两组治疗前后血气指标水平比较 治疗前,两组 PaO2、PaCO2、pH 水平比较,差异均无统计学意义(P>0.05);治疗后,两组 PaO2、pH 水平均明显高于治疗前,且观察组高于对照组,两组PaCO2 水平均明显低于治疗前,且观察组低于对照组,差异有统计学意义(P<0.05)。见表 2。
2.3 两组不良反应发生率比较 观察组不良反应发生率为 16.22%(12/74),与对照组的 13.51%(10/74)比较,差异无统计学意义(P>0.05)。见表 3。
3 讨论
泼尼松是临床常用的糖皮质激素类药物,有较好的抗炎、抗纤维化及抗氧化作用,还可抑制相关细胞因子的分泌,能延缓 IPF 病情进展 [7]。糖皮质激素类药物虽可在一定程度上缓解患者的临床症状,但无法快速改善患者的气道内环境 [8-9]。盐酸氨溴索是溴环己胺醇的盐酸盐,可加速分泌物排出体外,并提升肺表面活性物质的活性,有效减轻炎症反应,并抑制病灶区病原体的定植 [10]。
本研究结果显示,观察组治疗总有效率和PaO2、pH 水平均高于对照组,PaCO2 水平低于对照组,这一结果与文献报道相吻合 [11]。分析原因为氨溴索可协同泼尼松缓解急性加重期 IPF 患者的气道水肿和狭窄,同时快速清除分泌物,形成“抗炎 -排痰 - 气体交换”的良性循环,改善肺功能,优化血气指标水平,提高治疗效果 [12]。本研究结果同时显示,两组不良反应发生率比较,差异无统计学意义。提示联合应用氨溴索未增加安全风险。
综上所述,氨溴索联合泼尼松治疗 IPF 急性加重期患者,可提高治疗总有效率,改善血气指标水平,效果优于
单纯泼尼松治疗。
参考文献
[1] 马雪梅,王晶,李树民,等 . 特发性肺纤维化患者外周血 Th22细胞及相关因子的表达及临床意义 [J]. 齐齐哈尔医学院学报,2018,39(21):2486-2488.
[2] Richeldi L,du Bois RM,Raghu G,et al. Efficacy and safetyof nintedanib in idiopathic pulmonary fibrosis[J]. N Engl J Med,2014,370(22):2071-2082.
[3] Rogliani P,Calzetta L,Cavalli F,et al. Pirfenidone,nintedaniband N-acetylcysteine for the treatment of idiopathic pulmonaryfibrosi:A systematic review and meta-analysis[J]. Pulm Pharmacol Ther,2016(40):95-103.
[4] Homma S,Bando M,Azuma A,et al. Japanese guideline for the treatment of idiopathic pulmonary fibrosis[J]. Respir Investig,2018,56(4):268-291.
[5] 中华医学会呼吸病学分会间质性肺疾病学组 . 特发性肺纤维化诊断和治疗中国专家共识 [J]. 中华结核和呼吸杂志,2016,39(6):427-432..
[6] Sgalla G,Biffi A,Richeldi L. Idiopathic pulmonary fibrosis:Diagnosis,epidemiology and natural history[J]. Respirology,2016,21(3):427-437.
[7] 宋宁,段林 . 2015 ATS/ERS/JRS/ALAT 特发性肺间质纤维化指南解读 [J]. 临床荟萃,2015,30(9):1073-1080.
[8] Collard HR,Ryerson CJ,Corte TJ,et al. Acute exacerbationof idiopathic pulmonary fibrosis. an international working group report[J]. Am J Respir Crit Care Med,2016,194(3):265-275.
[9] Spagnolo P,Molyneaux PL,Bernardinello N,et al. The role of the lung’s microbiome in the pathogenesis and progression of idiopathic pulmonary fibrosis[J]. Int J Mol Sci,2019,20(22):5618.
[10] 何慧琳 . 特发性肺间质纤维化应用盐酸氨溴索 + 泼尼松治疗的效果分析 [J]. 临床医药文献电子杂志,2019,6(81):162.
[11] Marchioni A,Tonelli R,Ball L,et al. Acute exacerbation of idiopathic pulmonary fibrosis:lessons learned from acute respiratory distress syndrome[J]. Crit Care,2018,22(1):80.
[12] 谭毅 . 盐酸氨溴索联合糖皮质激素治疗特发性肺间质纤维化的临床研究 [J]. 临床合理用药杂志,2013,6(8):8-9.
关注SCI论文创作发表,寻求SCI论文修改润色、SCI论文代发表等服务支撑,请锁定SCI论文网!
文章出自SCI论文网转载请注明出处:https://www.lunwensci.com/yixuelunwen/34678.html